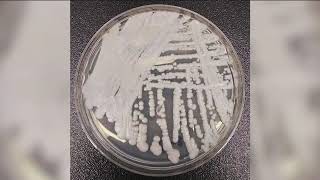
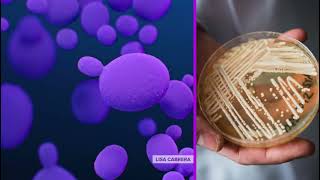

Growing concern over rise of fungal infections in healthcare facilities video
Online izle ve mp4 mp3 formatlarinda yukle

Videonun muddeti: 0:27
Growing concern over rise of fungal infections in healthcare facilities videosu mp4 ve mp3 yuklemek ucun hazirdir
Diqqet! Siz Mp4 yukle ve ya Mp3 yukle duymesine basdiqdan sonra eger sistem sizi reklam sehifesine atarsa o zaman derhal geri qayidib emeliyyati tekrar edin ve faylin yuklemek ucun hazir olmasini gozleyin
Videodan Mp4 Yukle
Videodan Mp3 Yukle-1
Videodan Mp3 Yukle-2
Oxshar Axtarishlar
 Growing concern over rise of fungal infections in healthcare facilities
Growing concern over rise of fungal infections in healthcare facilities Growing concern over rise of fungal infections in healthcare facilities
Growing concern over rise of fungal infections in healthcare facilities Doctors voice concerns over deadly fungal infection
Doctors voice concerns over deadly fungal infection Cases of deadly fungus grow in recent years; CDC warns of increasing threat
Cases of deadly fungus grow in recent years; CDC warns of increasing threat What to know about the drug-resistant fungus spreading in health care facilities
What to know about the drug-resistant fungus spreading in health care facilities Growing concern over deadly fungus spreading in U.S. health care facilities
Growing concern over deadly fungus spreading in U.S. health care facilities C. auris fungus can be stubborn, potentially deadly at long-term health care sites
C. auris fungus can be stubborn, potentially deadly at long-term health care sites Invasive fungal infections on the rise: How to protect those at risk
Invasive fungal infections on the rise: How to protect those at risk Fungal Infections: A Growing Health Concern
Fungal Infections: A Growing Health Concern
Video Mp4 Mp3Azwap.Biz
Azwap.Biz 2021-2023

Growing concern over rise of fungal infections in healthcare facilities
Growing concern over rise of fungal infections in healthcare facilities Growing concern over rise of fungal infections in healthcare facilities
Growing concern over rise of fungal infections in healthcare facilities Doctors voice concerns over deadly fungal infection
Doctors voice concerns over deadly fungal infection Cases of deadly fungus grow in recent years; CDC warns of increasing threat
Cases of deadly fungus grow in recent years; CDC warns of increasing threat What to know about the drug-resistant fungus spreading in health care facilities
What to know about the drug-resistant fungus spreading in health care facilities Growing concern over deadly fungus spreading in U.S. health care facilities
Growing concern over deadly fungus spreading in U.S. health care facilities C. auris fungus can be stubborn, potentially deadly at long-term health care sites
C. auris fungus can be stubborn, potentially deadly at long-term health care sites Invasive fungal infections on the rise: How to protect those at risk
Invasive fungal infections on the rise: How to protect those at risk Fungal Infections: A Growing Health Concern
Fungal Infections: A Growing Health Concern